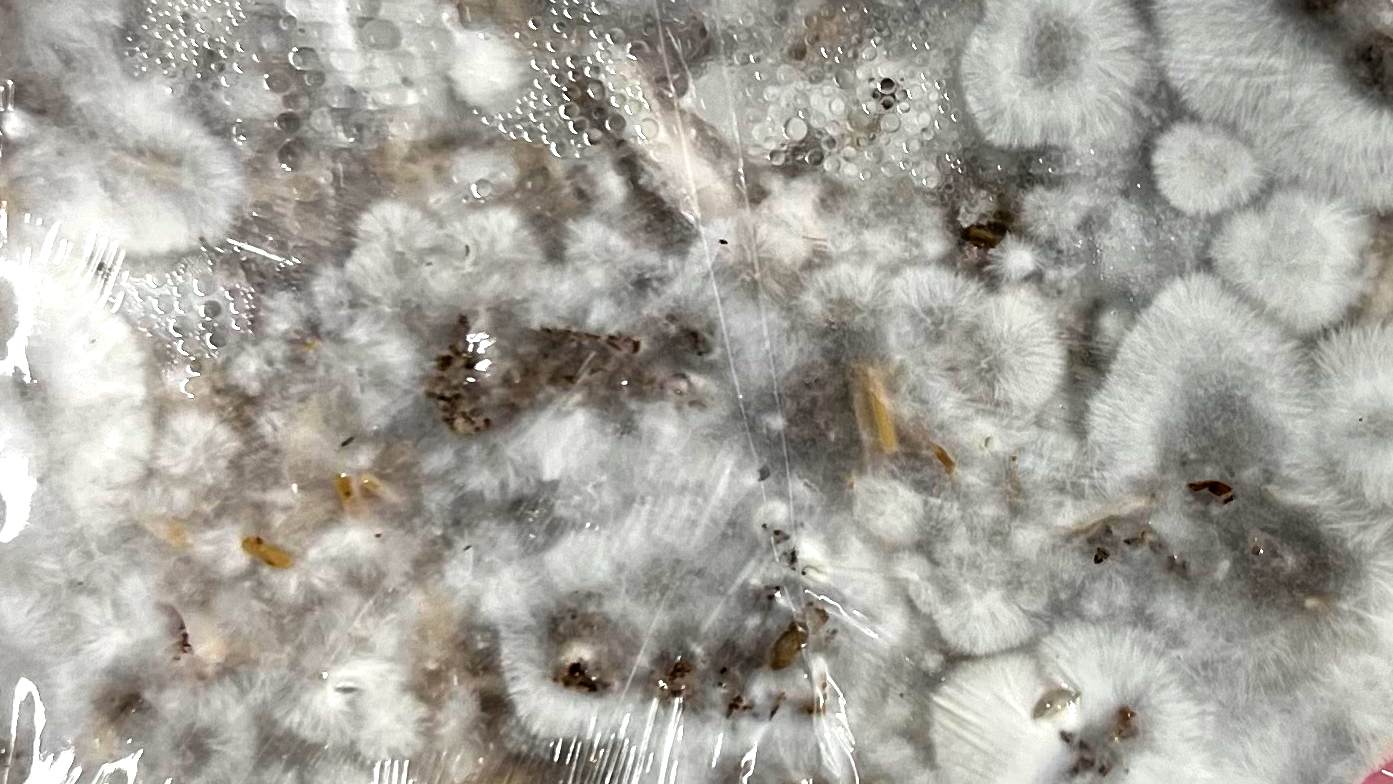

Royal College of Art
London
June 2025
London
June 2025
Living Vessels
In Living Vessels, the artist explores fungi as both a material and a collaborator, reimagining sustainable sculpture practices.
In Living Vessels, the artist explores fungi as both a material and a collaborator, reimagining sustainable sculpture practices.

Reflecting on her prior work as a muralist using materials harmful to the environment, she now questions traditional artistic choices and seeks to create works that coexist harmoniously with nature. Viewing mycelium as a co-collaborator, she plays music and engages in conversation with the organism during the creation process, fostering a unique bond with the living material. Each vase captures this unpredictable relationship, embracing outcomes such as over-incubation, insufficient ventilation, or excess condensation. The project highlights the beauty of process, care, and the potential for art to regenerate rather than harm, urging artists to critically examine their materials and practices.